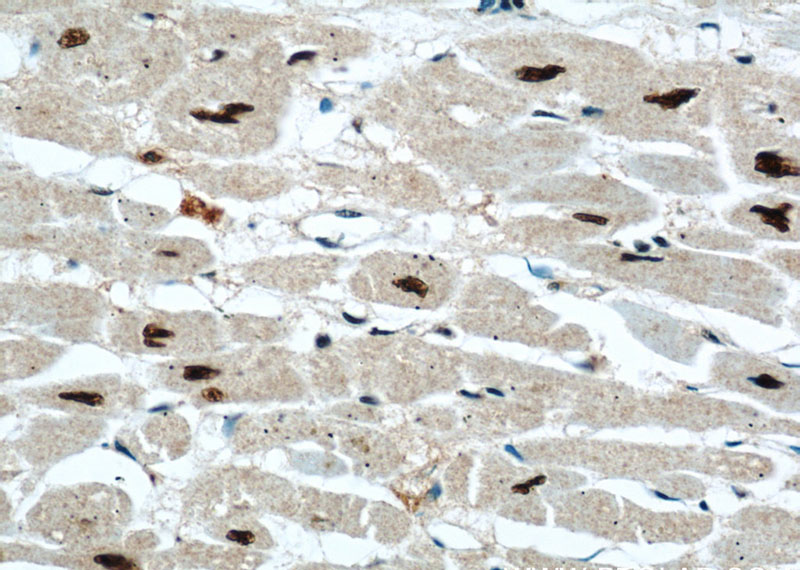
Immunohistochemical of paraffin-embedded human heart using Catalog No:112439(MAPKAP1 antibody) at dilution of 1:50 (under 40x lens)

-
Product Name
MAPKAP1 antibody
- Documents
-
Description
MAPKAP1 Rabbit Polyclonal antibody. Positive WB detected in mouse skeletal muscle tissue, HeLa cells. Positive IHC detected in human heart. Observed molecular weight by Western-blot: 37-42kd,55kd
-
Tested applications
ELISA, WB, IHC
-
Species reactivity
human, mouse, rat; other species not tested.
-
Alternative names
MAPKAP1 antibody; JC310 antibody; SIN1 antibody; SAPK interacting protein 1 antibody; mSIN1 antibody
-
Isotype
Rabbit IgG
-
Preparation
This antibody was obtained by immunization of Peptide (Accession Number: NM_024117). Purification method: Antigen affinity purified.
-
Clonality
Polyclonal
-
Formulation
PBS with 0.02% sodium azide and 50% glycerol pH 7.3.
-
Storage instructions
Store at -20℃. DO NOT ALIQUOT
-
Applications
Recommended Dilution:
WB: 1:500-1:5000
IHC: 1:20-1:200
-
Validations

mouse skeletal muscle tissue were subjected to SDS PAGE followed by western blot with Catalog No:112439(MAPKAP1 antibody) at dilution of 1:1000

Immunohistochemical of paraffin-embedded human heart using Catalog No:112439(MAPKAP1 antibody) at dilution of 1:50 (under 10x lens)
Immunohistochemical of paraffin-embedded human heart using Catalog No:112439(MAPKAP1 antibody) at dilution of 1:50 (under 40x lens)
-
Background
MAPKAP1, also named as MIP1 and SIN1, belongs to the SIN1 family. It is a subunit of mTORC2 which regulates cell growth and survival in response to hormonal signals. mTORC2 is activated by growth factors, but, in contrast to mTORC1, seems to be nutrient-insensitive. mTORC2 seems to function upstream of Rho GTPases to regulate the actin cytoskeleton, probably by activating one or more Rho-type guanine nucleotide exchange factors. Within mTORC2, MAPKAP1 is required for complex formation and mTORC2 kinase activity. MAPKAP1 inhibits MAP3K2 by preventing its dimerization and autophosphorylation. It inhibits HRAS and KRAS signaling. MAPKAP1 enhances osmotic stress-induced phosphorylation of ATF2 and ATF2-mediated transcription. The antibody is specific to MAPKAP1. The antibody can recognize all the isoform of MAPKAP1.
Related Products / Services
Please note: All products are "FOR RESEARCH USE ONLY AND ARE NOT INTENDED FOR DIAGNOSTIC OR THERAPEUTIC USE"
